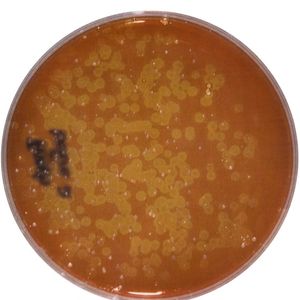

Working extra hard to clean & sanitize your home? What about your TOOTHBRUSH!
Working extra hard to clean & sanitize your home? What about your TOOTHBRUSH!
Our Goal Is To Help You Live Healthier!

Don't Brush Without it " It's A Must "

WITHOUT TOOTHBRUSH MATE

WITH TOOTHBRUSH MATE
The simplest, cleanest, and easiest way to protect your mouth from the harmful bacteria left on your toothbrush. When we brush our teeth we contaminate our toothbrush with all types of bacteria and left over food particles. These are invisible to the naked eye and can cause disease. As your toothbrush sits in your bathroom waiting for you to use it next, the harmful bacteria has time to grow and reproduce. This can cause gum disease and many other dental issues. According to studies, the contaminates on our toothbrush can also affect our overall heath. Many people don't realize, that airborne bacteria from your toilet can also contaminate your toothbrush. Toothbrush Mate solves this problem. Once you finish brushing your teeth, rinse your brush, tap dry, then soak your toothbrush in the Toothbrush Mate solution. Toothbrush Mate's patented, FDA approved formula will kill 99% of bacteria within 2 -3 minutes. Once this time is up, you can take your toothbrush out and rinse it under water, then place it in the toothbrush holder attached to our bottle. As your brush is being sanitized, our product will loosen the food particles and dead bacteria from your bristles; and they will fall into our patented funnel system. The dead particles will never touch your toothbrush again!

Check out this great video where Liz demonstrates just how easy it is to use Toothbrush Mate to sanitize your toothbrush.
Copyright © 2020 TOOTHBRUSHMATE - All Rights Reserved.
Powered by GoDaddy